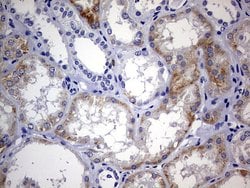

Promotional price valid on web orders only. Your contract pricing may differ. Interested in signing up for a dedicated account number?
Learn More
Learn More
Invitrogen™ ARL3 Monoclonal Antibody (OTI3A10)


Mouse Monoclonal Antibody
Supplier: Invitrogen™ MA526577
Description
ARL3 Monoclonal Antibody for Western Blot, IHC (P)
ADP-ribosylation factors (ARFs) are low molecular weight GTP-binding proteins belonging to the RAS superfamily. The predicted 182-amino acid ARL3 (ADP-ribosylation like factor) protein shares 97% amino acid identity with rat ARLl3 and 43% identity with human ARF1. Like the ARFs, ARL3 has a glycine at position 2, the site of N myristoylation, and lacks cysteine residues near the C terminus, which are found in other members of the RAS family. Northern blot analysis detected a 1-kb ARL3 transcript in all tissues tested, with highest expression in heart and lung, and lower expression in brain, liver, kidney, ovary, and testis. A 5.5-kb transcript was also detected in most tissues, with highest expression in brain. Immunoblot analysis detected ARL3 in human tumor cell lines but not in normal rodent cells. Although ARL3 binds GTP, it is devoid of activity in the cholera toxin-dependent ADP-ribosylation of Gs, and is therefore classified as an ARF-like protein.
Specifications
| ARL3 | |
| Monoclonal | |
| 1 mg/mL | |
| PBS with 1% BSA, 50% glycerol and 0.02% sodium azide; pH 7.3 | |
| P36405 | |
| Arl3 | |
| Human recombinant protein fragment corresponding to amino acids 2-182 of ARL3 produced in E.coli. | |
| 100 μL | |
| Primary | |
| Human | |
| Antibody | |
| IgG2a |
| Immunohistochemistry (Paraffin), Western Blot | |
| OTI3A10 | |
| Unconjugated | |
| Arl3 | |
| ADP ribosylation factor like GTPase 3; ADP-ribosylation factor like GTPase 3; ADP-ribosylation factor-like 3; ADP-ribosylation factor-like protein 3; ADP-ribosylation-like 3; ARD3; ARFL3; ARF-like 3; Arf-like protein 3; Arl3 | |
| Mouse | |
| Affinity chromatography | |
| RUO | |
| 403 | |
| -20°C, Avoid Freeze/Thaw Cycles | |
| Liquid |
Product Content Correction
Your input is important to us. Please complete this form to provide feedback related to the content on this product.
Product Title
Spot an opportunity for improvement?Share a Content Correction